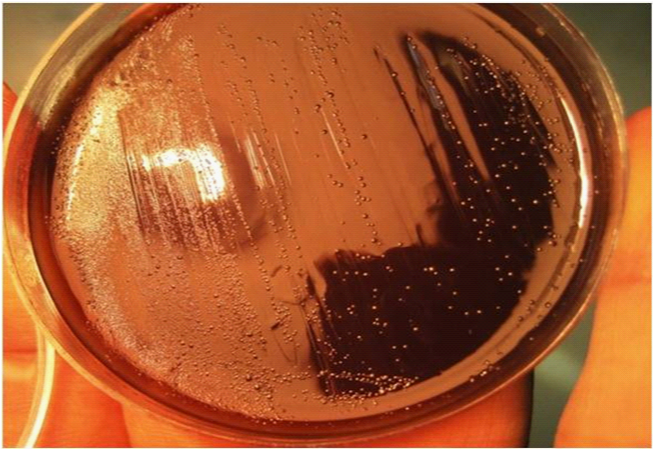

MOJ
eISSN: 2381-179X


Case Report Volume 1 Issue 1
Department of Bacteriology, Tarbiat Modares University, Iran
Correspondence: Amin Talebi Bezmin Abadi, Department of Bacteriology, Tarbiat Modares University, Tehran, Iran, Tel 14115-111
Received: October 14, 2014 | Published: November 13, 2014
Citation: Mobarez AM, Bezmin Abadi AT, Taghvaei T. A rare case of helicobacter pylori mix infections and recurrence of duodenal ulcers. MOJ Clin Med Case Rep. 2014;1(1):1-3 DOI: 10.15406/mojcr.2014.01.00001
Introduction: Since Helicobacter pylori (H. pylori) infection is a major cause of gastroduodenal ulcers, it is normal to expect successful eradication drastically reduces ulcer recurrence.
Case presentation: We present a case of a 45-year-old woman with no history duodenal ulcer in her family who was referred to the hospital with epigastric pain. A gastroduodenoscopy was then performed, and revealed two active duodenal ulcers, both measuring 10mm in size. She was prescribed with 14days H. pylori standard therapy, but no confirmation test concerning bacterial clearance was performed. Ten months later, she was admitted to the hospital again and complained about intense epigastric pain and vomiting. Gastroscopic findings showed a new 11mm duodenal ulcer. However, because of positive rapid urease test (RUT), further microbiological analysis was prescribed. Strikingly, H. pylori mix infections was observed. With prescription of second-line therapy against H. pylori, after 4weeks, positive 13C-urea breath test became negative and her duodenal ulcer was also completely cured.
Conclusion: Our cases strongly suggest that frequency of H. pylori mix infections is not only considerable but also it can drastically affect the final outcome of clinical manifestations such as duodenal ulcer. Conclusively, current report insists that gastroenterologists should pay more attention to the possibility of presence of H. pylori mix infections in the management of patients with duodenal ulcers. Additionally, after an initial antibacterial treatment, an obligatory follow up system is recommended.
Keywords: helicobacter pylori, duodenal ulcer, mixed infection
Helicobacter pylori (H. pylori) is a spiral Gram-negative bacterium that colonizes approximately one-half of the world’s population. Since its groundbreaking discovery in 1982 by Barry Marshall, H. pylori has been the topic of extensive digestive research. The infection is involved in the development of various gastroduodenal diseases including duodenal ulcer and gastric cancer.1 However, to everyone’s surprise, H. pylori infection in human stomach evades strong immune responses, leading to ineffective bacterial clearance.2 It has been firmly established that H. pylori colonization is associated with 90% of duodenal ulcers.3 In clinical setting, as a general rule, H. pylori testing is not recommended for asymptomatic individuals. However, there is no well-established guideline for symptomatic digestive patients infected with H. pylori. At the beginning, lack of this guideline was not thought to be a potential problem. Those patients with duodenal ulcers can usually be distinguished by severe clinical outcomes including bloating, lack of appetite, nausea and vomiting, particularly if left untreated.4 Along these lines, we report the case of a patient with duodenal ulcers in whom H. pylori had not been successfully eradicated. Undoubtedly, this report elucidates the rationale that H. pylori mixed infections should also be considered in the context of a patient’s clinical history and also further examination after first-line therapy to improve management of patients with duodenal ulcers. The low frequency of reports on duodenal ulcers linked with H. pylori mix infections motivated the presentation of the current case.
A 45-year-old woman had been admitted to the hospital presented with vomiting and epigastric pain of seven months duration and without specific histories in her family. A gastroduodenoscopy was then performed, and revealed two active duodenal ulcers, both measuring 10mm in size. Furthermore, histopathological examination showed an acute inflammation and H. pylori infection. Subsequent bacterial culture and PCR assay confirmed identity of H. pylori infection.5 Thus, she was treated for fourteen days with H. pylori standard therapy based on proton pump inhibitor (PPI)-amoxicillin-clarithromycin. Because of the likely poor patient adherence of medication, no clear records were available about her first admission. Due to absence of the patient and intense emotional stress, clearance of H. pylori infection after first-line therapy was not confirmed by a negative 13C-urea breath test or even a negative stool antigen test. Strikingly, 10months later, she again referred to the hospital due to the intense epigastric pain. Endoscopic findings confirmed new 11mm duodenal ulcer. Because of positive rapid urease test (RUT) at endoscopic room, further microbiological analysis prescribed.6 Since possible risk of mix infection, bacterial culture was performed to investigate H. pylori mix infections. In brief, from original plate (Figure 1), five different colonies were picked and restreaked in new plates according to the standard protocols.7,6 PCR of virulence genes, (e.g. cagA, iceA1, homB, babA2 and cagE) were carried out to detect and draw genetic variability panel of those H. pylori strains.8–10 Primer sequences, sizes, and conditions of PCR amplifications of the glmM gene for detection and confirmation of H. pylori and the other genes (i.e., homB, cagA, cagE, iceA1 and babA2), were carried out using the conditions described previously (Table 1).6,9,8 This time, after starting second-line therapy (levofloxacin-based therapy), within 4weeks, positive 13C-urea breath test became negative and her duodenal ulcer was also completely cured.11 The presence of H. pylori virulence genes was directly determined by specific sensitive PCR method, then results were compared per single strain (Table 2). The distribution of various H. pylori genotypes as shown in Table 2 indicates presence of mix infections. In a follow up system for this interesting case of up to 12months, no new abdominal pain, vomiting or any evidence to H. pylori infection were observed.
Figure 1 Original plate harboring at least 5 different H. pylori strains isolated from 45-years-old women.
Genes |
PCR product |
PCR conditions |
Reference |
cagA |
298bp |
95°C, 1min; 61°C, 1min; 72°C, 1min (33cycles) |
7 |
iceA1 |
247bp |
95°C 1min; 55°C, 1s; 72°C, 50 sec (35cycles) |
10 |
babA2 |
271bp |
95°C, 1min; 48°C, 1min; 72°C, 1min (32cycles) |
10 |
homB |
161bp |
95°C, 1min; 56°C, 1min; 72°C, 1min (30cycles) |
9 |
cagE |
508bp |
95°C, 1min; 52°C, 48s; 72°C, 55 s (30cycles ) |
9 |
glmM |
294bp |
94°C, 1min; 57°C, 1min; 72°C, 1min (30cycles) |
7 |
Table 1 Primer sequence and PCR conditions
H. pylor i Strains |
cagA |
iceA1 |
homB |
babA2 |
cagE |
A1 |
+ |
- |
+ |
- |
+ |
A2 |
+ |
+ |
+ |
- |
- |
A3 |
- |
+ |
+ |
- |
+ |
A4 |
+ |
- |
- |
+ |
- |
A5 |
- |
- |
- |
+ |
+ |
Table 2 Distribution of various virulence genes among five different picked colonies from original H. pylori plate
It should be noted that since differences exist in H. pylori DNA contents obtained from the same patient, the mixed infections might actually affect clinical outcome. However, an undeniable fact is that the majority of patients with duodenal ulcers are infected with H. pylori. Despite the long period of time that we have known about H. pylori we are not aware of main route of transmission. At least in developing countries, childhood is accepted as the most likely time of the first exposure with this persistent bacterium. Not enough evidence for zoonotic transmission of H. pylori infection is available yet.12,13 Collectively, human-human direct contact is considered the most possible route for H. pylori transmission. However, colonization of the human stomach by more than one strain at the same time is not an abnormal phenomenon in H. pylori microbiology. Concerning H. pylori treatment, around 25% of individuals are not cured completely; in this case, second line therapy is mostly recommended.14 nowadays, a therapeutic dilemma exists for patients who failed in first line antibacterial therapy.15 In fact, recurrence of H pylori after primary therapeutic is not rare in developing countries. Current knowledge is not quite conclusive that recurrence is caused by re-colonization of the same strain or recurrence of infection should be considered likely responsible by new H. pylori strain.15 Treatment of duodenal ulcers is strongly affected by successful clearance of H. pylori infection. The worst-case scenario would be that the H. pylori mix infections be incorporated. Altogether, the risk of carrying multiple resistant strains will be simultaneously increased,16 if primary H. pylori colonization is left uncured. We think if having mixed infection can influence the risk of DU recurrence; thereby it should be an alarming signal for clinicians and microbiologist to consider these types of strains as a risk factor to increase the clinical manifestations affected by H. pylori. In conclusion, recurrence of H. pylori re-infection should be taken into consideration. In other words, our findings support the notion that reliable approach for follow-up after H. pylori eradication should be used at least in regions such as developing countries, due to the relatively high rate of re-infection and mix infections. Because of easy and relatively free access of antibiotics in the developing countries, and also an increasing trend of antimicrobial resistance; an accurate follow-up system to confirm bacterial clearance (e.g. UBT or serologic tests) seems necessary in diagnostic procedures.
None
The author declares no conflict of interest.

©2014 Mobarez, et al. This is an open access article distributed under the terms of the, which permits unrestricted use, distribution, and build upon your work non-commercially.